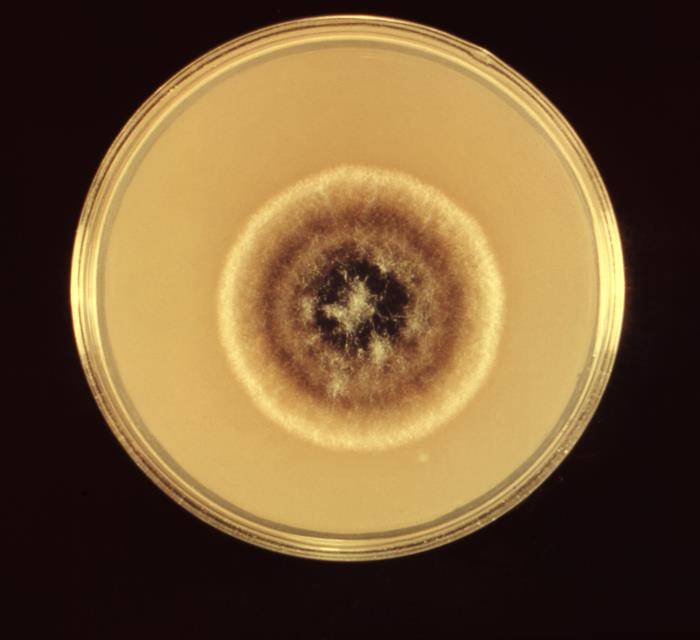
CDC Public Health Image Library (PHIL)

Alternaria es un hongo filamentoso, saprofito, perteneciente al filo Ascomycota y al grupo de los dematiáceos, caracterizados por presentar una coloración oscura.
Microscópicamente se observan conidióforos simples, tabicados, de forma alargada u ovoide. En el extremo del conidióforo se forman unos conidios de color pardo, con septos transversales y verticales (muriformes) de disposición irregular. La reproducción es por gemación de la célula apical, a partir de la cual se genera un nuevo conidio, formándose así largas cadenas de conidios.
Las colonias son de crecimiento rápido (tres o cuatro días) y macroscópicamente presentan un aspecto velloso, al principio de color gris, después adquieren tonos negros oliváceos en el centro y reverso y con un borde gris blanquecino que rodea la colonia.
Viabilidad, propagación y transmisión
Reservorio
Suelo, vegetales (madera enmohecida o vegetales en descomposición), alimentos (fruta fresca, cereales, frutos secos, hortalizas), fómites.
Hospedadores
Humanos y animales.
Dosis Infectiva Mínima (DIM)
Se desconoce en la actualidad.
Supervivencia ambiental
Ubiquista. Es un hongo patógeno de vegetales encontrándose principalmente en el suelo, en vegetales en descomposición (madera, frutas, cereales, hortalizas), en papel y tejidos (ropa, alfombras).
Para crecer necesita una humedad relativa entorno al 25 % - 30 %, siendo mayor su proliferación a humedades relativas más altas (superiores al 90 %). También puede crecer en un amplio rango de temperaturas de 2 ºC a 33 °C, y amplio rango de pH entre 2-8.
Las esporas se encuentran en forma de bioaerosol en el aire, alcanzando concentraciones pico a finales del verano y en otoño. Es un contaminante habitual en los edificios o en los lugares de trabajo, encontrándose en los sistemas de aire acondicionado y en las humedades generadas por condensación.
Formas de resistencia
Las esporas resisten la radiación ultravioleta y la desecación.
Mecanismo de propagación y transmisión
La transmisión se produce principalmente por contaminación de heridas o por inoculación del hongo a través de cortes o pinchazos con herramientas o elementos contaminados.
La inhalación de las esporas o de los fragmentos del micelio, presentes en forma de bioaerosol en los ambientes laborales, conduce a procesos de sensibilización o alergia. Su presencia en ambientes laborales se ha relacionado con el Síndrome del Edificio Enfermo (SEE) y con el síndrome tóxico por polvo orgánico (ODTS, fiebre del grano, micotoxicosis pulmonar).
Además, la ingesta de alimentos contaminados puede provocar intoxicaciones.
Se relaciona frecuentemente con casos de enfermedad nosocomial, principalmente por contaminación de heridas quirúrgicas.
No se produce transmisión de persona a persona.
Vías de entrada
Respiratoria. Percutánea. Digestiva.
Distribución geográfica
Mundial.
Efectos sobre la salud
Grupo de riesgo
Sin clasificar.
(Ver Anexo II RD 664/1997 )Infección
Feohifomicosis: son micosis causadas principalmente por A. alternata, A. infectoria y A. tenuissima, afectan principalmente a personas inmunocomprometidas. Normalmente son superficiales (p.ej. onicomicosis), cutáneas y subcutáneas (se manifiestan en forma de lesiones únicas o múltiples en forma de placas pardorrojizas, papulonodulares, pustulosas o ulcerocostrosas, localizadas en las superficies corporales expuestas como piernas, brazos, pies, abdomen, etc.) y, en raras ocasiones, sistémicas (p.ej. encefalitis).
También, se ha relacionado a A. alternata y A. infectoria con queratomicosis y endoftalmitis en personas que han sufrido un traumatismo o cirugía ocular.
Efectos alérgicos (Ver Anexo II RD 664/1997 ) / (Ver Allergen )
Rinitis alérgica, alveolitis alérgica extrínseca o neumonitis por hipersensibilidad (pulmón de los trabajadores de la pulpa de la madera) y asma (asma del panadero), por la inhalación de esporas o restos de micelio de Alternaria alternata, normalmente por la exposición a polvo de madera enmohecida (7) (10) (13).
Efectos tóxicos (Ver Anexo II RD 664/1997 )
Los efectos tóxicos están relacionados principalmente con intoxicaciones alimentarias, como consecuencia de la ingesta de alimentos contaminados.
La presencia de micotoxinas como ácido tenuazónico (TeA) de A. alternata y A. tenuissima se ha relacionado con un desorden hematológico en personas: Onyalai (trombocitopenia aguda con lesiones hemorrágicas orales) (2).
También la exposición por vía respiratoria a elevadas cantidades de polvo orgánico, en el que puede haber diferentes hongos, entre ellos Alternaria, se ha relacionado con el síndrome tóxico por polvo orgánico (ODTS, fiebre del grano, micotoxicosis pulmonar) (10).
Efectos cancerígenos (Ver International Agency for Research On Cancer - IARC )
No existen datos relevantes sobre la genotoxicidad y carcinogenicidad de las micotoxinas de Alternaria en estudios in vivo, aunque sí se han demostrado alteraciones precancerosas en la mucosa esofágica de ratones (2) (8).
Efectos en la maternidad
No se han descrito
Enfermedad
| CIE-10 | Nombre | Enfermedad de Declaración Obligatoria |
|---|---|---|
| B48.8 | Otras micosis especificadas | No |
Actividades laborales con riesgo
Clasificación Nacional de Actividades Económicas (CNAE)
| CNAE 2009 | Descripción |
|---|---|
| A0111 | Cultivo de cereales, distintos de arroz, leguminosas y oleaginosas |
| A0112 | Cultivo de arroz |
| A0113 | Cultivo de hortalizas, raíces y tubérculos |
| A0114 | Cultivo de caña de azúcar |
| A0116 | Cultivo de plantas para fibras textiles |
| A0119 | Otros cultivos no perennes |
| A0121 | Cultivo de la vid |
| A0122 | Cultivo de frutos tropicales y subtropicales |
| A0123 | Cultivo de cítricos |
| A0124 | Cultivo de frutos con hueso y pepitas |
| A0125 | Cultivo de otros árboles y arbustos frutales y frutos secos |
| A0126 | Cultivo de frutos oleaginosos |
| A0127 | Cultivo de plantas para bebidas |
| A0128 | Cultivo de especias, plantas aromáticas, medicinales y farmacéuticas |
| A0129 | Otros cultivos perennes |
| A0130 | Propagación de plantas |
| A0141 | Explotación de ganado bovino para la producción de leche |
| A0142 | Explotación de otro ganado bovino y búfalos |
| A0143 | Explotación de caballos y otros equinos |
| A0144 | Explotación de camellos y otros camélidos |
| A0145 | Explotación de ganado ovino y caprino |
| A0146 | Explotación de ganado porcino |
| A0147 | Avicultura |
| A0148 | Otras explotaciones de ganado |
| A0150 | Producción agrícola combinada con la producción ganadera |
| A0161 | Actividades de apoyo a la agricultura |
| A0162 | Actividades de apoyo a la ganadería |
| A0163 | Actividades de preparación posterior a la cosecha y tratamiento de semillas para reproducción |
| A0170 | Caza, captura de animales y servicios relacionados |
| A0220 | Explotación de la madera |
| A0230 | Recolección de productos silvestres, excepto madera |
| A0240 | Servicios de apoyo a la silvicultura |
| C1032 | Elaboración de zumos de frutas y hortalizas |
| C1039 | Otro procesado y conservación de frutas y hortalizas |
| C1310 | Preparación e hilado de fibras textiles |
| C1611 | Aserrado y cepillado de la madera |
| C1621 | Fabricación de chapas y tableros de madera |
| C1628 | Fabricación de otros productos de madera, artículos de corcho, cestería y espartería |
| E3600 | Captación, depuración y distribución de agua |
| E3700 | Recogida y tratamiento de aguas residuales |
| E3811 | Recogida de residuos no peligrosos |
| F4211 | Construcción de carreteras y autopistas |
| F4212 | Construcción de vías férreas de superficie y subterráneas |
| F4213 | Construcción de puentes y túneles |
| F4221 | Construcción de redes para fluidos |
| F4291 | Obras hidráulicas |
| F4299 | Construcción de otros proyectos de ingeniería civil n.c.o.p. |
| F4312 | Preparación de terrenos |
| F4313 | Perforaciones y sondeos |
| G4611 | Actividades de intermediarios del comercio al por mayor de materias primas agrarias, animales vivos, materias primas textiles y productos semielaborados |
| G4622 | Comercio al por mayor de flores y plantas |
| G4623 | Comercio al por mayor de animales vivos |
| G4631 | Comercio al por mayor de frutas y hortalizas |
| N7210 | Investigación y desarrollo experimental en ciencias naturales y técnicas |
| N7500 | Actividades veterinarias |
| O8121 | Limpieza general de edificios |
| O8122 | Otras actividades de limpieza industrial y de edificios |
| O8123 | Otras actividades de limpieza |
| O8130 | Actividades de jardinería |
| R8699 | Otras actividades sanitarias n.c.o.p. |
| S9111 | Actividades de bibliotecas |
| S9112 | Actividades de archivos |
| S9122 | Actividades de sitios históricos y monumentos |
| S9141 | Actividades de los jardines botánicos y los parques zoológicos |
| S9311 | Gestión de instalaciones deportivas |
| S9329 | Actividades recreativas y de entretenimiento n.c.o.p. |
| T9630 | Pompas fúnebres y actividades relacionadas |
Clasificación Nacional de Ocupaciones (CNO)
| CNO 2011 | Descripción |
|---|---|
| 2130 | Veterinarios |
| 2210 | Profesores de universidades y otra enseñanza superior (excepto formación profesional) |
| 2421 | Biólogos, botánicos, zoólogos y afines |
| 2422 | Ingenieros agrónomos |
| 2423 | Ingenieros de montes |
| 2424 | Ingenieros técnicos agrícolas |
| 2425 | Ingenieros técnicos forestales y del medio natural |
| 2426 | Profesionales de la protección ambiental |
| 2427 | Enólogos |
| 2432 | Ingenieros en construcción y obra civil |
| 2454 | Ingenieros geógrafos y cartógrafos |
| 2462 | Ingenieros técnicos de obras públicas |
| 2483 | Ingenieros técnicos en topografía |
| 2821 | Sociólogos, geógrafos, antropólogos, arqueólogos y afines |
| 2911 | Archivistas y conservadores de museos |
| 2912 | Bibliotecarios, documentalistas y afines |
| 3132 | Técnicos en instalaciones de tratamiento de residuos, de aguas y otros operadores en plantas similares |
| 3141 | Técnicos en ciencias biológicas (excepto en áreas sanitarias) |
| 3142 | Técnicos agropecuarios |
| 3143 | Técnicos forestales y del medio natural |
| 3313 | Técnicos en anatomía patológica y citología |
| 3314 | Técnicos en laboratorio de diagnóstico clínico |
| 3327 | Ayudantes de veterinaria |
| 4121 | Empleados de control de abastecimientos e inventario |
| 4122 | Empleados de oficina de servicios de apoyo a la producción |
| 4123 | Empleados de logística y transporte de pasajeros y mercancías |
| 4210 | Empleados de bibliotecas y archivos |
| 4221 | Empleados de servicios de correos (excepto empleados de mostrador) |
| 4301 | Grabadores de datos |
| 4309 | Empleados administrativos sin tareas de atención al público no clasificados bajo otros epígrafes |
| 4411 | Empleados de información al usuario |
| 4412 | Recepcionistas (excepto de hoteles) |
| 4421 | Empleados de agencias de viajes |
| 4422 | Recepcionistas de hoteles |
| 4423 | Telefonistas |
| 4424 | Teleoperadores |
| 4430 | Agentes de encuestas |
| 4441 | Cajeros de bancos y afines |
| 4442 | Empleados de venta de apuestas |
| 4443 | Empleados de sala de juegos y afines |
| 4444 | Empleados de casas de empeño y de préstamos |
| 4445 | Cobradores de facturas, deudas y empleados afines |
| 4446 | Empleados de mostrador de correos |
| 4500 | Empleados administrativos con tareas de atención al público no clasificados bajo otros epígrafes |
| 5892 | Empleados de pompas fúnebres y embalsamadores |
| 5893 | Cuidadores de animales y adiestradores |
| 5992 | Bañistas-socorristas |
| 5993 | Agentes forestales y medioambientales |
| 6110 | Trabajadores cualificados en actividades agrícolas (excepto en huertas, invernaderos, viveros y jardines) |
| 6120 | Trabajadores cualificados en huertas, invernaderos, viveros y jardines |
| 6201 | Trabajadores cualificados en actividades ganaderas de vacuno |
| 6202 | Trabajadores cualificados en actividades ganaderas de ovino y caprino |
| 6203 | Trabajadores cualificados en actividades ganaderas de porcino |
| 6205 | Trabajadores cualificados en la avicultura y la cunicultura |
| 6209 | Trabajadores cualificados en actividades ganaderas no clasificados bajo otros epígrafes |
| 6300 | Trabajadores cualificados en actividades agropecuarias mixtas |
| 7250 | Mecánicos-instaladores de refrigeración y climatización |
| 7295 | Personal de limpieza de fachadas de edificios y chimeneas |
| 7618 | Artesanos en tejidos, cueros y materiales similares, preparadores de fibra y tejedores con telares artesanos o de tejidos de punto y afines |
| 7833 | Cortadores de tejidos, cuero, piel y otros materiales |
| 8155 | Operadores de máquinas para tratar pieles y cuero |
| 8193 | Operadores de máquinas de embalaje, embotellamiento y etiquetado |
| 8331 | Operadores de maquinaria de movimientos de tierras y equipos similares |
| 9210 | Personal de limpieza de oficinas, hoteles y otros establecimientos similares |
| 9229 | Otro personal de limpieza |
| 9441 | Recogedores de residuos |
| 9442 | Clasificadores de desechos, operarios de punto limpio y recogedores de chatarra |
| 9443 | Barrenderos y afines |
| 9511 | Peones agrícolas (excepto en huertas, invernaderos, viveros y jardines) |
| 9512 | Peones agrícolas en huertas, invernaderos, viveros y jardines |
| 9520 | Peones ganaderos |
| 9530 | Peones agropecuarios |
| 9543 | Peones forestales y de la caza |
| 9601 | Peones de obras públicas |
| 9602 | Peones de la construcción de edificios |
| 9603 | Peones de la minería, canteras y otras industrias extractivas |
| 9700 | Peones de las industrias manufactureras |
| 9811 | Peones del transporte de mercancías y descargadores |
Prevención y control
Desinfectantes
Fenólicos, yodóforos, glutaraldehído 2% y formaldehído.
Inactivación física
Se inactiva por calor húmedo a 121ºC durante al menos 15 minutos.
Antimicrobianos
Itraconazol, anfotericina B, voriconazol y posaconazol.
Vacunación
No disponible
Medidas preventivas generales
Disponer de ventilación adecuada en los lugares de trabajo, evitar la humedad relativa alta y las condensaciones.
Orden y limpieza en el lugar de trabajo. Implantar un programa periódico de limpieza y mantenimiento de locales, instalaciones y equipos, especialmente en el sistema de climatización-ventilación del edificio.
Almacenar los productos de origen vegetal o animal: alimentos, residuos orgánicos, paja, madera, cereales, etc. en condiciones relativamente secas y en recintos bien ventilados para prevenir el enmohecimiento.
Desechar o eliminar los alimentos enmohecidos.
Evitar procesos pulvígenos o que generen bioaerosoles; si no es posible, cerramiento o aislamiento de dichos procesos o disponer de un sistema de extracción localizada.
Adoptar unas correctas medidas de higiene, no comer, ni beber en el lugar de trabajo, lavado de manos, evitar la exposición de heridas abiertas, utilizar ropa de trabajo y equipos de protección individual.
Precauciones en centros sanitarios
En hospitales o centros sanitarios, adoptar las Precauciones Estándar (12).
EPI
Protección respiratoria: mascarillas autofiltrantes por lo menos FFP2, o máscaras con filtros P2 en tareas que puedan generar bioaerosoles o polvo.
Protección ocular: gafa de protección de montura universal en caso de riesgo de contacto accidental mano/guante contaminado-ojo, o pantalla de protección facial (símbolo de marcado en montura: 3) en caso de riesgo de exposición a salpicaduras, o gafa de protección de montura integral con hermeticidad frente a partículas (símbolo de marcado en montura: 4), en caso de riesgo de exposición a polvo.
Protección de las manos: guantes impermeables y de cierta resistencia mecánica en la manipulación de materiales contaminados (madera enmohecida).
Seguridad en laboratorio
Nivel de contención: 2
El riesgo de contraer una infección en laboratorio es bajo. El principal riesgo es la inoculación accidental o contaminación de heridas y los efectos alérgicos por la inhalación de bioaerosoles contaminados.
Las muestras más peligrosas son cultivos del hongo o muestras procedentes del suelo o de productos contaminados como: madera, cereales, frutos secos, etc.
Se requieren las prácticas y las medidas de contención de un nivel 2 de bioseguridad. Evitar el empleo de material cortante o punzante. Utilizar cabina de seguridad biológica clase II en aquellas operaciones que impliquen la generación de bioaerosoles, proyecciones o salpicaduras y la manipulación de cultivos del hongo; también se deben usar guantes impermeables en la manipulación o contacto con muestras contaminadas.
Bibliografía
- Henn, S. L., & Forrest, G. N. (2006). Febrile neutropenia associated with painful lesions of the palms and digits. Clinical Infectious Diseases, 43(6), 747-792. DOI: 10.1086/507033.
- Pavón, M. A., González, I., Martín de Santos, R., & García, T. (2012). Importancia del género Alternaria como productor de micotoxinas y agente causal de enfermedades humanas. Nutrición Hospitalaria, 27(6). DOI: 10.3305/nh.2012.27.6.6017.
- Pontón, J., Moragues, M. D., Gené, J., Guarro, J., & Quindós, G. (2002). Hongos y actinomicetos alergénicos. Revista Iberoamericana de Micología.
- Rubio, M. C., Gil, J., Benito, T. R., Ramírez de Ocáriz, I., & Navarro, M. (2007). Micosis más frecuentes en nuestro medio. En Guía práctica de identificación y diagnóstico en micología clínica (2ª ed.) (Capítulo 2). Revista Iberoamericana de Micología.
- Rubio, M. C., Rezusta, A., & Gil, J. Infecciones oculares por el género Alternaria. Sociedad Española de Enfermedades Infecciosas y Microbiología Clínica (SEIMC).
- Centers for Disease Control and Prevention (CDC). (2020). Biosafety in microbiological and biomedical laboratories (6th ed.).
- Comisión de Salud Pública del Consejo Interterritorial del Sistema Nacional de Salud. Ministerio de Sanidad y Consumo. (2000). Protocolo de vigilancia sanitaria específica para los/as trabajadores/as expuestos a Neumonitis por Hipersensibilidad o Alveolitis Alérgica Extrínseca.
- European Food Safety Authority (EFSA). (2011). Scientific opinion on the risks for animal and public health related to the presence of Alternaria toxins in feed and food. EFSA Journal, 9(10), 2407. DOI: 10.2903/j.efsa.2011.2407.
- Institut National de Recherche et de Sécurité (INRS). Documents pour le médicin du travail, nº 119 (TC 128) y nº 121 (TC 131).
- Institut National de Santé Publique du Québec. (2002). Les risques à la santé associés à la présence de moisissures en milieu intériur.
- Instituto Nacional de Seguridad y Salud en el Trabajo (INSST). Notas Técnicas de Prevención (NTP): 288, 299, 313, 335, 351, 409, 488, 539, 771, 802 y 822.
- Servicio Riojano de Salud. (2008). Precauciones de aislamiento en centros sanitarios.
- Thermo Fisher Scientific. (2021). Alternaria alternara. Allergy & autoinmune disease: Allergen encyclopedia.
- World Health Organization (WHO). Regional Office for Europe. (2009). WHO Guidalines for indoor air quality: dampness and mould.